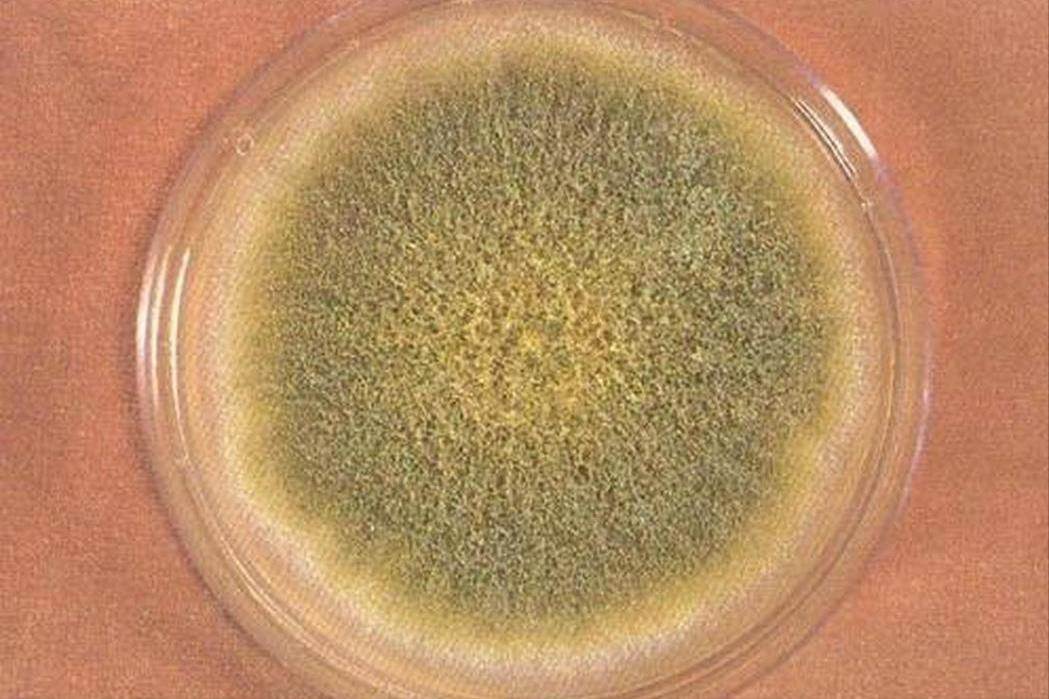

4 種堅果攜帶毒素,致癌還傷肝,醫生道出實情:別再吃了

腰果
腰果因其柔軟細膩的口感,常被用于零食和烹飪中, 但這類堅果在儲存時同樣容易受到黃曲霉素的污染。
有一位喜歡自制堅果零食的家庭主婦,在用散裝腰果制作甜點后,發現家中一位成員出現了肝區不適和噁心癥狀, 檢查發現肝功能指標異常,而根源就出在她選購的低價散裝腰果上。

腰果的油脂含量高,而油脂容易吸附空氣中的水分,
在濕熱環境下,霉菌會迅速繁殖并生成黃曲霉素。
腰果表面雖然光滑,但霉菌和毒素可能隱藏在果仁內部, 這種污染往往肉眼難以察覺。
如果腰果沒有妥善儲存或在運輸過程中受潮,這些隱形的威脅會隨食物進入體內,損害肝臟。

選擇腰果時,應盡量選購真空包裝或經過品質檢驗的產品, 不要購買散裝或外包裝不密封的腰果。
儲存腰果時,
可以將其放在密封袋中,并置于低溫干燥的環境中, 如果發現腰果有酸敗的味道或者表面油膩發黑,應立即丟棄。

榛子
榛子以其獨特的風味和高營養價值成為許多人的零食選擇, 但它的硬殼并不意味著完全隔絕霉菌的侵害。
一位老年患者因肝功能持續異常來到醫院就診,排除了病毒性肝炎和其他常見病因后,發現他長期食用的榛子是問題的關鍵。

這些榛子是朋友從農戶手中購買的,因儲存不當,很多榛子已經受潮發霉, 但因為外殼完好,問題并未被察覺。
榛子的外殼雖然堅硬,但如果采摘后處理不當,殼內的果仁容易積累水分, 成為霉菌繁殖的溫床。

黃曲霉素一旦形成,
就可能附著在果仁表面, 而裂開的榛子殼則進一步增加了污染的可能性。
研究發現,長期攝入含黃曲霉素的食品,即使劑量微小,也可能通過慢性肝損傷誘發肝硬化甚至肝癌。
對于榛子等帶殼堅果,選購時一定要挑選殼表面光滑、無裂縫的產品, 并盡量選擇經過專業處理和包裝的品牌堅果。

儲存時,讓環境保持干燥通風, 不要讓榛子處在陽光直射和高濕度的地方。
要是發現榛子的味道、氣味異常,或者果仁顏色轉為黑色,就一定不要吃了。
花生、開心果、腰果和榛子,這些廣受歡迎的堅果雖然營養豐富,但如果儲存和加工不當,可能成為黃曲霉素的「藏身之所」, 對肝臟健康構成極大的威脅。

黃曲霉素屬于一級致癌物,它不僅致癌級別高,而且會以慢性作用的形式,加劇肝臟的負荷, 致使肝硬化和肝癌的發病風險升高。
為了避免這些隱患,我們在選購和儲存堅果時,一定要保持謹慎, 優先選擇經過正規渠道檢測的產品,杜絕散裝或來源不明的堅果入食。
如果堅果出現異味、顏色異常或其他可疑情況, 必須果斷丟棄,切勿因小失大,每一口健康的堅果都來源于科學的選擇,而這也是保護肝臟的重要一步。
以上內容僅供參考,若身體不適,請及時咨詢專業醫生
關于黃曲霉素您有什麼看法?